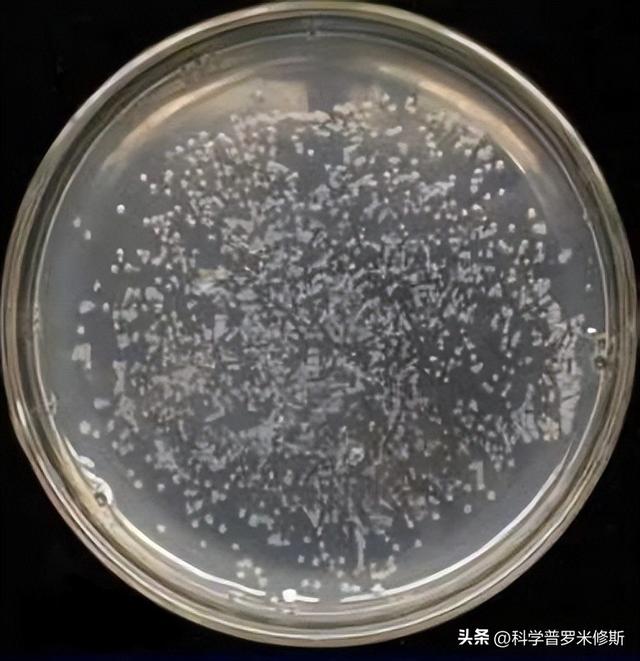
图片
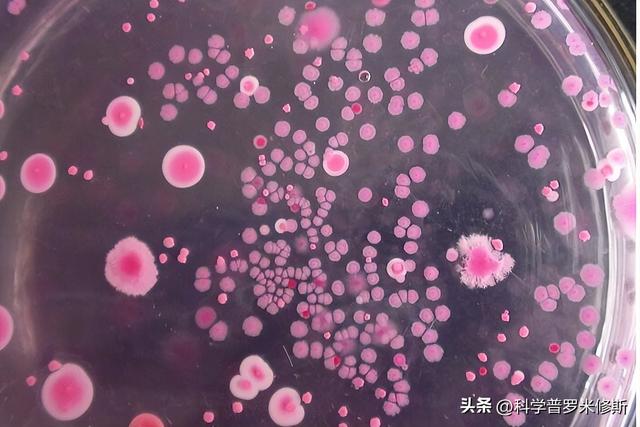
图片
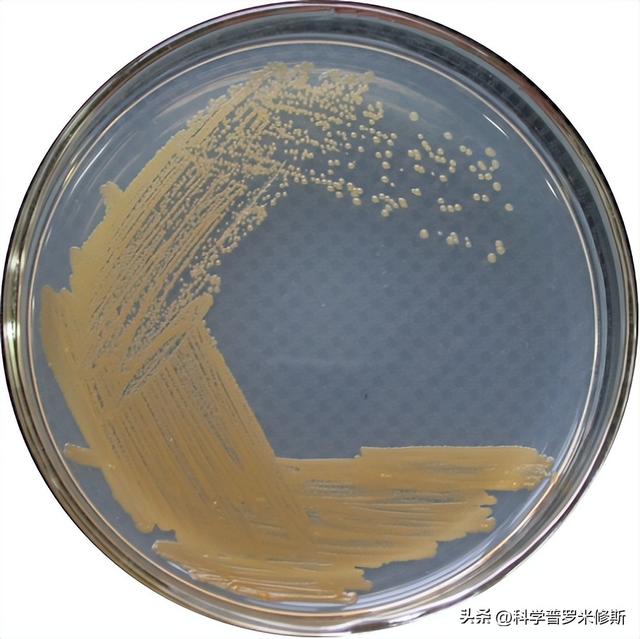
图片

别看微生物个子小,
可它们也是生命体,“一日三餐”不可或缺。
那么科研人员在研究微生物的过程中,是怎样
“饲喂”这些小不点的呢?
接下来,让我们一探究竟。
01
培养基的故事

科赫/细菌学之父
说起微生物培养,就不得不提“细菌学之父”德国人罗伯特·科赫(Robert Koch)。中肯评价,他对微生物学的贡献非常之大。
1880年,科赫工作于柏林帝国医院。这一时期,他对细菌学的研究不仅没有放下,反而在研究方法上实现了创新。
液体培养基
在以往的研究中,人们均采用液体培养基培养细菌。然而,七七八八的细菌混合生长在一起,对其进行分离培养几乎是不可完成的任务。而善于思考和发现的科赫,则是在一次偶然之中发明了可凝固体培养基。
可凝固体培养基
当时,他将明胶混入了以土豆消煮液为主要原料的液体培养基中,然后将其倒在一块玻璃板上,待冷凝之后,一层固体培养基便出现在了玻璃板表面,光滑、细腻(看起来有点像果冻布丁)。

后来在他人建议下,科赫又以材料性质更佳的琼脂替代明胶,使得固体培养基在常温下也能完好保持形态,并沿用至今。
可不要小看科赫的这一发明,它在微生物学史上具有里程碑意义。在此基础上,科赫创立了固体培养基划线分离纯种微生物法。
不同种类的细菌个体可在固体培养基上定点生长,并通过连续的分裂繁殖在其上形成一个个大小、形态和颜色各异的菌落。
某一菌落的所有细菌必定源自同一先祖,从种属分类角度来看是纯的。有了这些菌落,科学家们可以根据各自的研究目的,非常方便地将其转移到其他培养基、生物体或物品之上。

科赫运用他所创立的这一方法,首次实现了炭疽杆菌的分离和培养。之后,他又发现和分离了结核杆菌,并认定这一微生物是引发结核病的病原体。

1882年3月下旬的某一天,他将自己关于结核杆菌的研究在柏林生理协会举办的会议上进行了宣讲,获得了与会者的一致认可和赞同,而他当天的举措也载入了人类医学史。
科赫利用纯培养法成功地否定了当时关于微生物形态变化多端的错误认知,但他坚信微生物形态固定不变的想法,也是有时代局限性的。
02
什么是培养基
培养基/Medium
培养基英文名为Medium,它是人工配置的养料集合,一般包含微量元素、碳源、氮源、生长因子(如氨基酸、维生素、抗生素和血清等)和水等成分。不同的培养基配置原料不同,使用方法各异。
根据不同的分类标准,可将培养基分成若干种类:
化学分类
天然培养基
以化学成分不明的天然物质配制而成的培养基,如人体血浆
组合培养基
如基础无机盐培养基
半组合培养基
如马铃薯蔗糖培养基
物理分类
固体培养基
半固体培养基
液体培养基
脱水培养基
微生物分类
细菌培养基
如牛肉膏蛋白胨培养基
放线菌培养基
如高氏一号
微藻培养基
如BG-11培养基
真菌培养基
如马铃薯蔗糖培养基
功能分类
选择性培养基
可使混合菌群中的目的微生物成为优势菌,如酵母菌富集培养基
鉴别培养基
用于特定微生物鉴别,如伊红美蓝培养基
03
配置原则

配置原则/注意事项
1.要选择适合的配置原料(浓度和比例要恰当)
不同种类的微生物各自营养需求不同,要根据其特点进行针对性的配置。例如,自养微生物能够自己合成有机物,其培养基组分完全可由简单无机物组成。
2.注意控制酸碱度(pH)
一般而言,细菌培养基偏碱性(pH大于7),真菌培养基偏酸性。另外,一些培养基中还有两性电解质或缓冲对存在,具备一定的缓冲能力。
3.氧化还原电位要合适
通常好氧微生物氧化还原值(F值)在 0.1伏以上,而厌氧微生物F值小于 0.1伏。
4.原料成本
所取原料应价廉、易得,这一点在用量颇大的工业发酵领域尤为重要。
5.灭菌与存放
培养基配置完成后,要严格灭菌,以防污染杂菌。灭菌后的培养基最好立刻使用,如无法立即使用的应于避光、防潮和阴凉处存放。
04
实践

实操/心动不如行动!
林林总总介绍了这么多,有条件的同学可以试着动手制作培养基,并体验一下“饲养”微生物的乐趣,会很有成就感的呦。